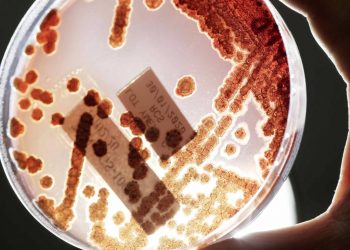

Consejo de Seguridad de la ONU abordará el proceso de paz en Colombia y sus múltiples desafíos
La semana anterior, el máximo representante de Naciones Unidas reiteró su preocupación por las amenazas a la consolidación de la paz en ese territorio. Al cumplirse el quinto aniversario de la firma del Acuerdo de Paz en esa nación suramericana, Guterres destacó los numerosos desafíos que aún tienen por delante.
20/01/2022
Las infecciones por bacterias multirresistentes causan más muertes que el sida o la malaria
20/01/2022
Acto de presentación en Madrid de la Campaña para la Contracumbre OTAN 8 de febrero de 2022
20/01/2022